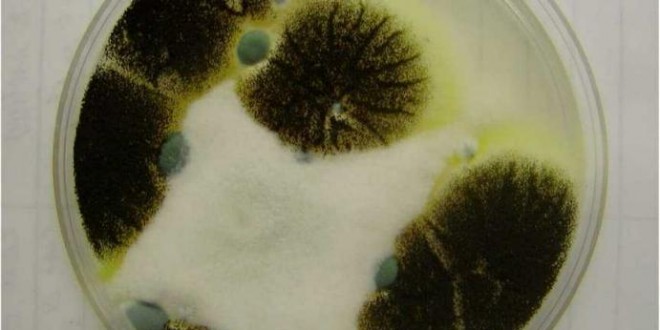
کپک مواد غذایی

عوامل قارچی فساد مواد غذایی به عوامل کپکی و مخمری تقسیم میشوند. کپکها آن دسته از قارچها هستند که غالبا بیماری خطرناکی ایجاد نمیکنند، اما گاهی در مواقع ضعف سیستم ایمنی بدن میتوانند بسیار خطرناک باشند.
عاملی که باعث گسترش و افزایش آنها میگردد، مقدار بیش از حد رطوبت است و پخت غذاها نیز نمی تواند سموم آنها را از بین ببرد. بنابراین برای امنیت و سلامت بیشتر، بهتر است که آنها را دور ریخت.
۱۲۰هزار جنس از گونه کپک ها وجود دارند که روی مواد غذایی قادرند رشد کنند. ۴۰ نوع آنها بیماریزا هستند و مابقی میتوانند مسمومیت غذایی ایجاد کنند. اما عدهای از آنها مفید هم هستند و در صنایع لبنی کاربرد دارند.
برای فاسد شدن غذا و میوه، کپک باید رشد کند و تغییرات فیزیکی و شیمیایی ایجاد کند تا با ترشح آنزیم اول رنگ آنهارا به هم بزند و دوم اینکه طعم شان را تغییر دهد و آنها را ترش مزه کند
آیا کپکها با هم متفاوت اند؟
کپکی که روی میوهها از جمله گلابی و سیب رشد میکند، روی ترشیها رشد نمیکند. کپکی که روی مربا تشکیل میشود، از ویژگیهای بیشتری برخوردار است، چون میتواند قند را تجزیه کند. کپکهایی که روی نان رشد میکنند، میتوانند بسیار خطرناک باشند. کپکهایی که روی گردو، پسته و انواع مغزها رشد میکنند، بسیار خطرناکتر از کپکهای میوهها هستند، چون از خود مادهای ترشح میکنند که گاه منجر به نقایص تولد و دگرگونیهای ژنتیکی میشود و یا سرطانزا هستند.
برای خیلی از ما پیش آمده که حتی وقتی غذا یا میوهای را در یخچال نگهداری کردیم، باز هم کپک زده و مجبور شدیم آن را دور بریزیم. خیلی از ما نمیدانیم چه کنیم که مواد غذایی در یخچال و یا محیط آشپزخانه کپک نرنند. طرفندهای متعدد میاندیشیدیم اما باز هم از شر این کپکها در امان نیستیم. باید به خاطر داشته باشیم که خوراکیها و مواد غذایی در یخچال همیشه تازه نمیمانند و روزی خواهد رسید که حجم زیادی از آنها را دور میریزیم و شک میکنیم که آیا این مواد خوراکی هنوز سالم هستند یا اینکه فاسد شدهاند؟
بسیار مهم است که بدانیم کدام یک از مواد غذایی و خوراکی به محض آنکه در یخچال قرار می گیرند، ماندگاری و طول عمر کمتری دارند و سریع تر فاسد می شوند. اگر مواد خوراکی که برای تهیه غذا در یخچال نگهداری می شوند، پس از گذشت یک مدت طولانی مورد مصرف قرار بگیرند، می توانند موجب فاسد شدن غذایی که ما مصرف می کنیم شوند و در نهایت خطرات و مشکلات بسیار جدی برای سلامت ما ایجاد می کنند.
کپک چیست و چگونه و چرا ایجاد میشوند؟
عوامل قارچی فساد موادغذایی به عوامل کپکی و مخمری تقسیم میشوند. کپکها آن دسته از قارچها هستند که غالبا ایجاد بیماری خطرناکی نمیکنند اما گاهی در مواقع ضعف سیستم ایمنی بدن میتوانند بسیار خطرناک باشند و تغییراتی از جمله تولید مواد سمی کنند که برای انسانها بسیار مضر و حتی کشنده است کپک ها در محیط های خیلی مرطوب رشد می کنند و عاملی که باعث گسترش و افزایش آنها می گردد، مقدار بیش از حد رطوبت است و پخت آنها نیز نمی تواند سموم آنها را نابود کند و از بین ببرد. بنابراین برای امنیت و سلامت بیشتر، بهتر است که آن را دور بریزید.. ۱۲۰ هزار جنس از گونه کپک وجود دارد. که روی موادغذایی قادرند رشد کنند. ۴۰ عدد آنها بیماریزا هستند و مابقی میتواند مسمومیت غذایی ایجاد کنند. حتی بعضیها میتوانند سرطانزا باشند. اما عدهای از آنها مفید هم هستند و در صنایع لبنی کاربرد دارند. کپکها به علت مناسب بودن شرایط رشد یعنی رطوبت و دما به سرعت رشد میکنند و میتوانند سبب تخریب و غیرقابل مصرف شدن میوهها و غذاها شوند. کپکها دارای رنگهای مختلفی بوده و کرکی شکل و پنبه مانند هستند و در محدوده وسیعی از درجه حرارت و PH میتوانند زنده بمانند. حرارت، اکسیژن، رطوبت از علت رشد کپکها است. کپکها به اشکال متعدد رشد میکنند و با تولید آنزیمهای زیاد سبب فساد غذاها میشوند. برای فاسد شدن غذا و میوه کپک باید رشد کند و تغییرات فیزیکی و شیمیایی ایجاد کند با ترشح آنزیم اولا سفتی غذاها و رنگ آنها به هم بزند و آن را لزج کند. دوم تغییر طعم ایجاد کند و سوم مزه آنها را به هم بزند یعنی ترشمزه کند.
آیا کپکها با هم فرق دارند؟
بله. همه کپکها با هم متفاوتاند. برای مثال کپکی که روی میوهها از جمله گلابی و سیب رشد میکند روی ترشیها رشد نمیکند. کپکی که روی مربا تشکیل میشود، از خصوصیات بیشتری برخوردار است چون میتواند قند را تجزیه کند. کپکهایی که روی نان رشد میکنند میتوانند بسیار خطرناک باشند. کپکهایی که روی گردو، پسته و انواع مغزها رشد میکنند و چرکتاپ هستند و به رنگ تیره هستند بسیار خطرناکتر از کپکهای میوهها هستند. چون از خود مادهای ترشح میکنند که گاه منجر به نقایص تولد و دگرگونیهای ژنتیکی شد، و یا سرطانزا هستند.
چگونه میتوان مانع کپک زدن نان شد؟
از آنجایی که کپکها در نان قادرند ریشهدار شده و در بافت نان فرو رو ند بسیار خطرناکتر هستند بنابراین زمانی که نانها لایه لایه روی هم قرار گرفتهاند و یکی از لایهها کپک زده است باید تمام نانها دور ریخته شود چرا که کپک به همه قسمتهای دیگر هم نفوذ کرده است. بنابراین پیش از سرد شدن کامل نانها نباید آنها دسته کنید. زیرا حرارت نان موجب کپکزدگی زودرس میشود. انباشته شدن نان داغ پیش از سرد شدن موجب تغییر حالت ظاهری بیات شدن زودرس، تسریع در کپکزدگی و بیماریهای گوارشی میشود. بنابراین برای جلوگیری از کپک زدن نان باید در پلاستیکهای دربسته و در فریزر نگهداری کنید. حتی یخچال موجب بیات شدن و کپک زدن نان میشود. پیچیدن نان در پارچههای سفید و بیرنگ بهتر از سفرههای پلاستیکی است زیرا رطوبت در پارچه وجود ندارد و ماندگاری نان بیشتر میشود.
درباره میوهها چه باید کرد؟
لابد برای شما هم پیش آمده که وقتی میوه ها را در قسمت جا میوه ای پایین یخچال قرار می دهید بعد از چند روز کم کم شروع به کپک زدن کرده وخراب می شوند . میوهها حتی با وجود شستن در یخچال کپک میزنند علت آن هم آبی است که بتدریج در جا میوه ای جمع می شود ونیز رطوبت دائمی یخچال .چنانچه یک قطعه اسفنج ا در جامیوه ای قرار دهید رطوبت وآبها را جذب کرده ومانع کپک زدگی میشود .
بنابراین نباید به مدت طولانی میوه ها را نگهداری کرد. بنابراین پس از شستن میوهها در جای خنک برای مثال با یک پنکه آنها را کاملا خشک کنید درون یک ظرف دربسته قرار دهید تا هم ماندگاری آن بیشتر شود و هم کپکترند. در صورتی که میوهای بسیار رسیده و لک دار است باید از سایر میوه ها جدا شود همچنین زمانی که میوهای کپک زد باید آن را از سایر میوهها جدا کرد و کل میوه را دور انداخت جدا کردن بخشی از میوه که کپک زده است و مصرف سایر قسمتها دلیل بر سلامت آن بخش نیست. بنابراین در صورت کپکزدگی میوه همه میوه را دور بیندازید. پوره کردن میوهها یکی دیگر از روشهای نگهداری میوه برای زمانی طولانی است
 .
.
آیا برداشتن بخشی از پنیر و کره کپک زده و مصرف مابقی اشکالی دارد؟
پنیر کپک زده خطرناک است چون میکروبهای دیگری دارد که ممکن است سبب زخم معده شوند. درباره پنیر میتوان بخش کپک زده را جدا کرد و مابقی را مصرف کرد. اما کره کپک زده بسیار خطرناک است چرا که کپکها کره را تجزیه میکنند، کره اکسید شده و حتی خطر سکته را به دنبال دارد. کلا چربیهای اکسید شده بسیار خطرناک هستند.
درباره کپک رب و مربا چه تدبیری اندیشه شود؟
یکی از دلایل کپک زدن مربا آن است که کاملا پخته نشده است. همچنین اگر قند مربا زیر ۲۷ درصد باشد بهطورمعمول کپک میزند استفاده از ظروف مناسب دردار که هوا به آنها وارد نمیشود در نگهداری مربا بسیار موثر است و میتواند مانع تشکیل کپک روی آن شود..اگر مربا کپک زده باشد میتوان یک لایه از روی آن برداشت و بقیه مربا را دوباره پخت بهتر است. بهتر است هنگام تهیه مربا از قاشق چربی استفاده شود،.
روش دیگری که میتوان مانع از کپک زدن است استفاده از کاغذ پرگامان یا همان کاغذ روغنی است که میتوان در سطح و با قرارداد، با این کار مانع از رسیدن هوا به مربا میشویم و از کپک زدن جلوگیری میشود. برای پیشگیری از کپک ربها نیز میتوان یک لایه روغن در سطح آنها مالید که عمل اکسیژنرسانی متوقف شده و از تشکیل کپک جلوگیری میشود. در این صورت حتی لازم نیست رب در یخچال گذاشته شود و میتوان در محیط خارج هم از آن نگهداری کرد. برای پیشگیری از کپک آبقوره و سرکه هم باید توجه کنید که تا سر شیشه از این مواد پر شود و هوا نداشته باشد. این شیشهها را درون ظرف بزرگی پر از آب قرار دهید و روی شعله بگذارید تا آب جوش بیاید. به مدت ۶ دقیقه این شیشهها را بجوشانید تا تمام سلولهای رویشی کپک درون آبقوره و سرکه از بین برود.
دکتر ابوالفتح شجاعی
فوقتخصص میکروبیولوژی مواد غذایی
بازدیدها: 362
 Fooda.ir صنایع غذایی فودآ
Fooda.ir صنایع غذایی فودآ